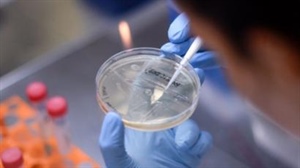

أخبار محلية
لقاح فيروس كورونا: الصين تتوقع إنتاجه بنهاية العام
بكين – العمانية
أفادت وسائل إعلام حكومية في الصين بأن أحد اللقاحات المحتملة لفيروس كورونا قد يكون جاهزا بحلول نهاية العام، أي قبل الموعد المتوقع له.
وقال رئيس المجمع الصيني للصناعات الصيدلانية، لوي جينغزهان، للقناة الفضائية الصينية إن شركته ستفرغ من المرحلة الأخيرة من الاختبارات على البشر في غضون ثلاثة أشهر. وكانت الشركة أعلنت في يونيو عن تأخر الاختبارات إلى العام المقبل لقلة عدد الإصابات الجديدة في الصين.
ولكنها الآن شرعت في إجراء اختبارات المرحلة الثالثة على آلاف الأشخاص في الإمارات. وتجري شركة صينية أخرى تستعمل تقنيات مماثلة اختبارات على البشر للقاح فيروس كورونا المحتمل في البرازيل.
ولكن منظمة الصحة العالمية لا تزال متحفظة إزاء اللقاح الصيني المحتمل، قائلة إنها تتوقع إنتاج عقار فعال مطلع العام المقبل.
وتطور الصين لقاحا محتملا آخر عن طريق شركة كانسينو ووحدة البحوث العسكرية، يبدو أن نتائجه إيجابية، إذ أظهرت العينات المختبرة مناعة ضد الفيروس في المراحل الأولى من الدراسة.
ويبحث القائمون على المشروع عن إمكانية إجراء اختبارات المرحلة الثالثة خارج الصين.



